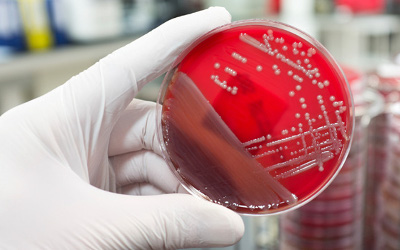
infectious-diseases

AKIPRESS.COM - Scientists have developed a new blood test that could detect whether or not a person will develop Alzheimer’s disease within three years, The Irish Times reported.
Scientists have developed a new blood test that could detect whether or not a person will develop Alzheimer’s disease within three years, The Irish Times reported.
A new study, published in the journal Nature Medicine, identified 10 molecules in blood could be used to predict with at least 90% accuracy whether people will go on to develop Alzheimer’s disease.
It is the first research which has been able to show differences in biomarkers in the blood between people with Alzheimer’s disease before the symptoms occur and people who will not go on to develop the condition.
The finding has potential for developing treatment strategies for Alzheimer’s at an earlier stage – when therapy would be more effective at slowing or preventing onset of symptoms, the authors said.
Researchers from Georgetown University Medical Center in the U.S. examined 525 healthy participants aged 70 and over and monitored them for five years. During the research, 28 participants went on to develop the conditions and 46 were diagnosed at the start of the study.
Mid-way through the research, the authors analyzed 53 patients who already had one of the conditions and 53 “cognitively normal” people.
They discovered 10 molecules which appeared to reveal the breakdown of neural cell membranes in participants who develop symptoms of cognitive impairment or Alzheimer’s disease.
They then tested other participants’ blood to see whether these biomarkers could predict whether or not they would go on to develop the conditions.
The blood test offers the potential to identify people at risk for progressive cognitive decline and can change how patients, their families and treating physicians plan for and manage the disorder.
This research could also give clues on how Alzheimer’s disease occurs and warrants further study, but as such a small number of people showed dementia symptoms there need to be larger studies with different populations before it could be turned into a blood test for Alzheimer’s disease.
